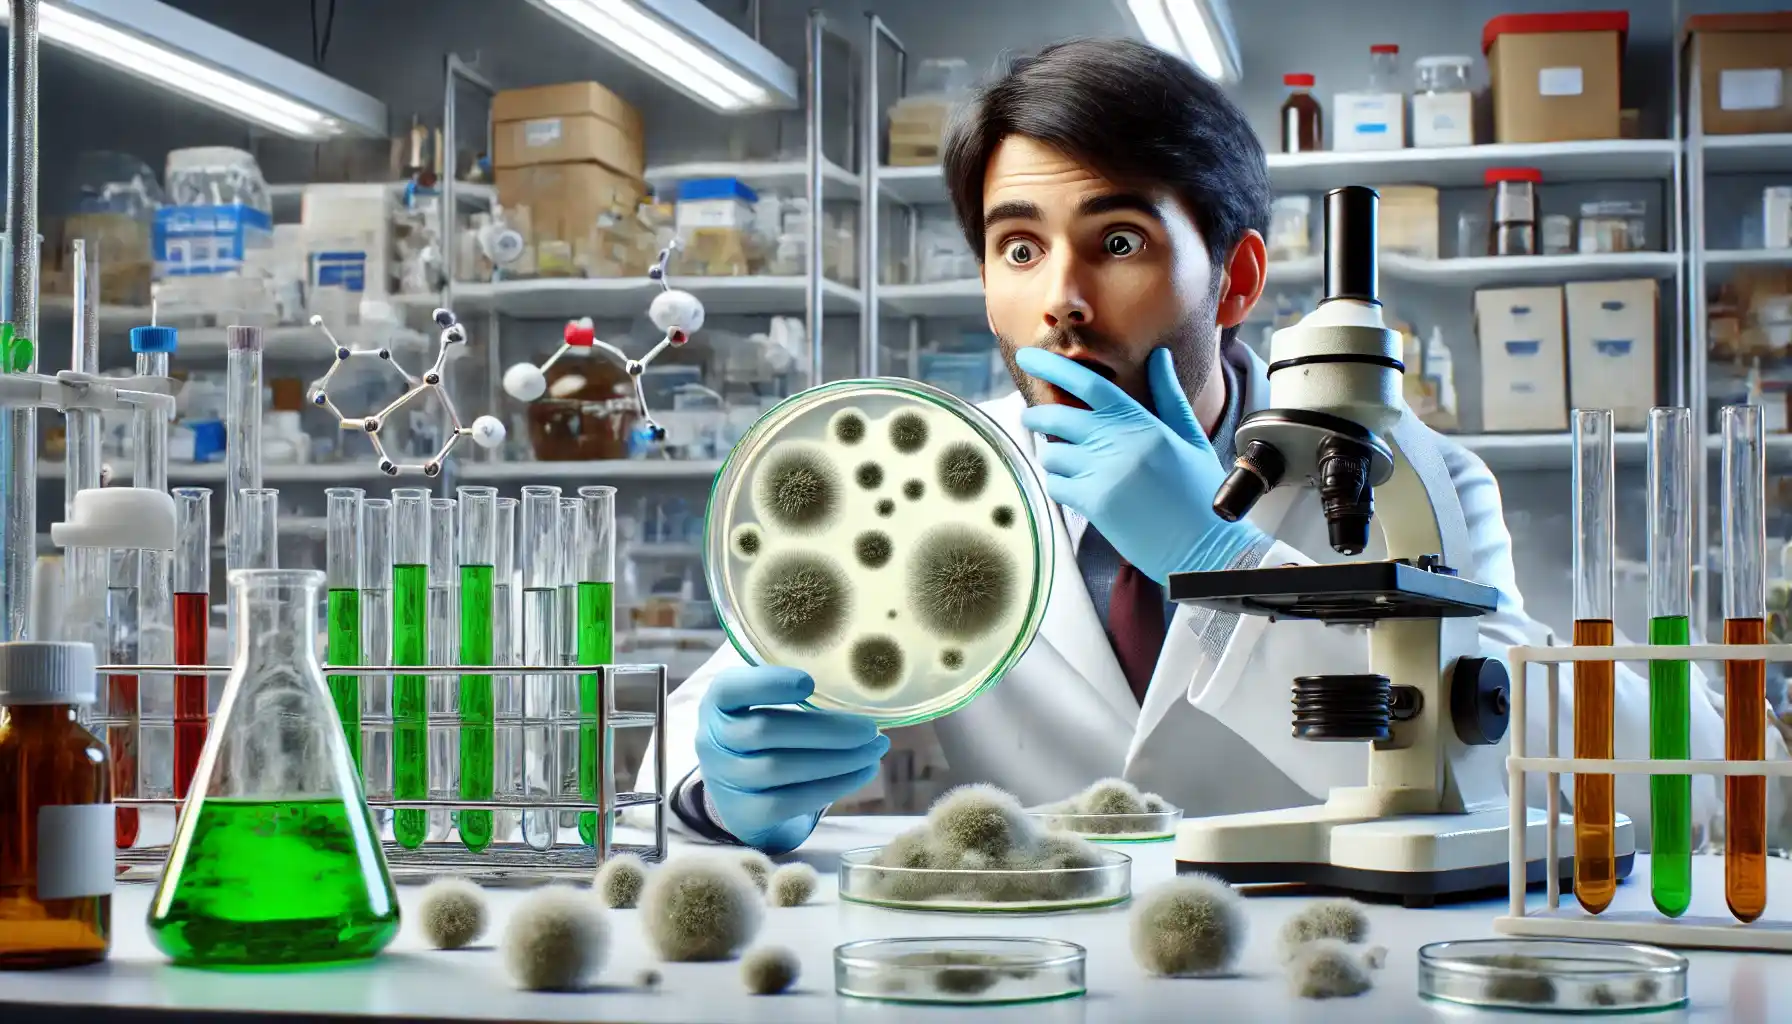
A scientist in a laboratory, surrounded by research equipment, is looking surprised at a petri dish where mold is growing.

You know that some of the most revolutionary technological innovations have resulted not through careful planning, but rather through chance, unexpected observations, and fortunate mistakes. Scientists and inventors often try to solve one problem, while bumped into something completely different - something that will change the world.
This phenomenon is similar to the world of collectibles, where the rarest and most valuable coins were originally minted by mistake. Without the right tools, many of these jewels would have gone unnoticed, just like the accidental inventions that took a while to gain recognition. Today, collectors use the best coin value app to determine the value of rare coins so that true riches are not overlooked. Similarly, researchers should recognize the potential of accidental discoveries, enabling them to develop into transformative technologies. So let us discuss them in more detail.
Discoveries from the Lab
These inventions were the result of scientific research but the process of discoveries took an unexpected direction. And the main lesson they show: Sometimes, the biggest breakthroughs happen when researchers take a step back and observe and some unintended effects of a technology can be even more valuable than its original purpose.
Penicillin – the first accidental cure for infections
One of the most famous accidental discoveries in the history of medicine, Penicillin, was discovered in 1928 when Scottish scientist Alexander Fleming left a petri dish of bacteria on his lab bench while he went on vacation. When he returned, he noticed that the mold (Penicillium notatum) had killed the surrounding bacteria.
At first, Fleming did not realize the magnitude of his discovery. However, further research led the scientist to the creation of the world's first antibiotic treatment. And with the passage of time this discovery has saved millions of lives. Before this breakthrough, bacterial infections (such as pneumonia and pharyngitis) were often fatal, but due to this accidental discovery old medicine has revolutionized, paving the way for the creation of antibiotics that continue to fight infections today.
Microwave oven – a side effect of military technology
The microwave oven, today's staple kitchen appliance, should never have been invented. In the 1940s, American engineer Percy Spencer was working with radar technology for the military. While testing magnetrons, he noticed that the candy bar in his pocket melted when exposed to microwave radiation.
Fascinated by this phenomenon, Spencer conducted further experiments, placing popcorn kernels and even an egg next to the device - both reacted strongly, proving that microwaves could be used to heat food. This led to the creation of the first commercial microwave oven in 1947, which was originally the size of a refrigerator. Over time, the technology was improved, and today we have modern examples: compact and available to households around the world.
Unusual Discoveries in Everyday Life
Some of the world's most useful technologies were not born in a laboratory, but were discovered in everyday situations by watching people. The main lesson here is that we should remember about curiosity and observation in daily life that can lead us to groundbreaking innovations.
Velcro – inspired by nature
Not all great inventions come from laboratories - some are concealed from prying eyes. In 1941, Swiss engineer Georges de Mestral noticed something unusual while walking his dog. When he returned home, he found tiny burrs from plants stuck to his clothes and his dog's fur.
Instead of brushing them off and moving on, de Mestral became curious. He examined small sticky things under a microscope and noticed that they had tiny hooks that naturally clung to the fibers. Due to this observation Velcro, the famous hook-and-loop fastener, was created. Now it is used almost everywhere: in clothing, shoes, and even space suits.
Coca-cola – a medical tonic that became a global phenomenon
In 1886, pharmacist John Pemberton was developing a new headache remedy. And according to the receipt the drink contains coca leaves and kola nuts to give it a stimulating effect.
But one day it so happened that his assistant accidentally mixed the medicinal syrup with carbonated water instead of regular water. The result? John Pemberton received a refreshing fizzy drink that became wildly popular. So the man quickly realized that people liked the taste and rebranded the mixture not as a medicine, but as a health-enhancing, refreshing drink.
Finally this drink is considered as a basis for the creation of Coca-Cola, one of the most recognizable brands in the world (which now sells more than 1.9 billion servings a day).
Accidental Discoveries in Manufacturing
Some of the most game-changing technologies were born from factory mistakes, overlooked errors, or unexpected reactions in industrial processes. These discoveries prove that even failures and accidents can lead to revolutionary innovations if you handle it with curiosity and persistence.
Coins – rare mistakes turned into riches
You should already realize that all valuable things are created intentionally - some become valuable because of mistakes. This saying is especially true those coins, where minting errors can turn an ordinary example into a collector's dream.
One famous example is the 1804 silver dollar, a coin that was never intended for mass circulation. It was minted in limited quantities and later it became one of the most expensive coins in history (with some selling for millions at auctions). Other coins, such as double die pennies or those with minting errors, are also highly sought after by collectors.
But without the right tools, these valuable examples can go unnoticed. This is where modern technology comes to the rescue - apps like Coin ID Scanner help collectors identify rare coins, preventing these jewels from slipping through the radar.
Super glue – an invention no one wanted
In 1942, engineer Harry Coover was working on materials for airplane windshields when he accidentally created a chemical compound that stuck to everything it touched. At the time, the discovery disappointed the inventor and was considered an embarrassing failure rather than a breakthrough.
Years later, Coover realized that his so-called “failed formula” had incredible adhesive properties. That's how superglue, one of the strongest and most widely used adhesives in the world, suddenly appeared to the world.
Tide detergent – a cleaning revolution from a lab mistake
When scientists at Procter and Gamble were developing a new soap formula, they accidentally set off a chemical reaction that produced a highly effective cleaning compound. In contrast to traditional soap, this new substance people were able to use to cope with grease and stains at the molecular level.
You'd be surprised, but the results are unpredictable. In this way people received Tide laundry detergent, a product that has revolutionized laundry care and become one of the best-selling cleaning products in the world.

Chance + Technology = Progress
Sometimes chance and technology go hand in hand, creating innovations that change the world. Each accidental discovery reminds us that progress does not always follow a set path - sometimes all you need to do is be alert and open to new possibilities.
